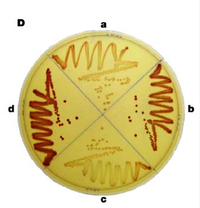

Talk:20.109(F11): Journal Club I
Identifying your mutant candidates
Last time in lab you electroporated the reporter cells with a library of phosphatasing mutants. The transformed cells were selected based on their antibiotic resistances (Ampicillin, Chloramphenicol and Kanamycin) and today you will screen the transformants for a colony or two that have the phenotype you are looking for. Recall that you are hoping to find a variant of Cph8 that makes the S-gal media lighter when the mutant cells are grown in the light. To find a cell with such a behavior, you might think that plating the cells on S-gal would be most productive approach. Unfortunately when the photography strain is plated on top of S-gal (as opposed to embedded in the agar) the color cells grown in the light and in the dark are both dark black. A different indicator media is needed, one that will vary in the range of enzyme activities that are relevant for our screen.
We will use the indicator dye 2-3-5-triphenyl tetrazolium chloride (TTC), which is pH sensitive and turns red when it is reduced. When b-gal catalyzes the hydrolysis of lactose into glucose and galactose, it changes the pH by providing simple sugars for the cell to metabolize. Since H+ is a byproduct of metabolism and TTC is a pH indicator, the cells growing on lactose with TTC change color. The colonies are red when the b-gal activity is low and less red or white when the activity is high.
From "The art and design of genetic screens: Escherichia coli" here's why:
Lactose tetrazolium agar is a rich medium that contains tetrazolium. All cells that grow on this medium reduce the tetrazolium to an insoluble formazan dye. However, robust acid production by lactose fermentation prevents formazan formation. So, strongly Lac+ strains produce white colonies, whereas weakly Lac+ or Lac- strains produce red colonies.
Before we move to Journal club today, you and your partner should choose two candidates from your electroporation plates. To choose your candidates, try to find reasonably well isolated colonies to compare so you will have a clonal population to study. Then look for colonies of about the same size but different colors. The size of the colonies matters since very small colonies may not have metabolized as much lactose based simply on their reduced number of cells rather than the activity of the signaling pathway in that cell.

Once you have chosen your favorite 2 candidates, circle the colonies with a sharpie on the back of the petri dish, and then give the petri dish to the teaching faculty so the colony can be restreaked for additional colonies and then grown at 37° in the light and dark in LB+Amp25+Cam34+Kan10 liquid media in advance of the next lab.